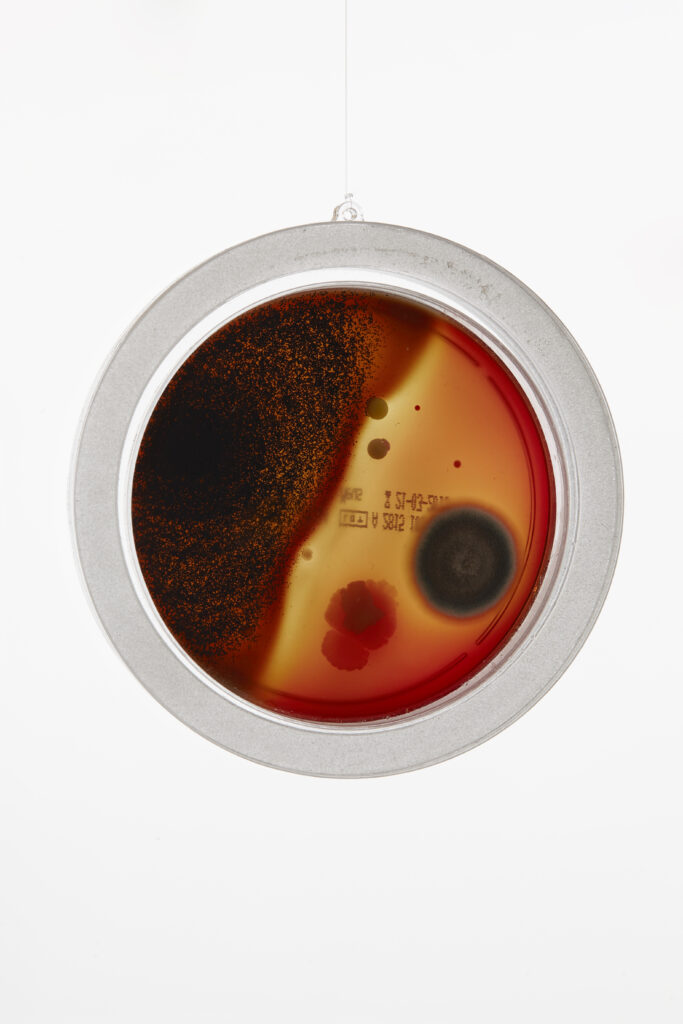
Opera Giordano dettaglio

Il pane e le rose
curated by Marco Meneguzzo
March 25 - July 17, 2015
Fondazione Arnaldo Pomodoro, Via Vigevano 9, Milano
With the group exhibition Il pane e le rose, curated by Marco Meneguzzo, the Foundation reflects on the theme of EXPO 2015, highlighting the human need to nourish not only the body but also the spirit.
The expression “Il pane e le rose”, coined by Marx, taken up by the American suffragettes and adopted by the labor movement since 1912, masterfully summarizes the need to associate bread with the deep necessity of nourishment through bonds and emotional projects, and roses with the need to cultivate passions, acquire knowledge, and weave social relationships. The image the curator wanted to imprint on the exhibition is that of art as a metaphor for the problem, rather than as a “document” of the existing. For this reason, five artists were chosen, each different in terms of genre, generation, and poetic approach – Gianni Caravaggio, Loris Cecchini, Chiara Dynys, Pino Deodato, and Giuseppina Giordano – whose common thread was the ability to develop a theme, a condition, through fantastic metaphors that depart from the immediate relation with the problem, only to subtly return to it in a more universal and enduring way, propelled by the powerful force of allegory.
Accompanying the exhibition, the fifth issue of the Quaderni presents a critical essay by Marco Meneguzzo, illustrates the works installed in the exhibition space, and provides insight into the research and activities of each artist.
Info and how to access the exhibition
When: March 25 – July 17, 2015, from Wednesday to Friday (11:00 AM – 7:00 PM)
Where: via Vigevano 9, Milano
Free entry
Contacts:
info@fondazionearnaldopomodoro.it
tel. 02 89075394
With the Patronage of